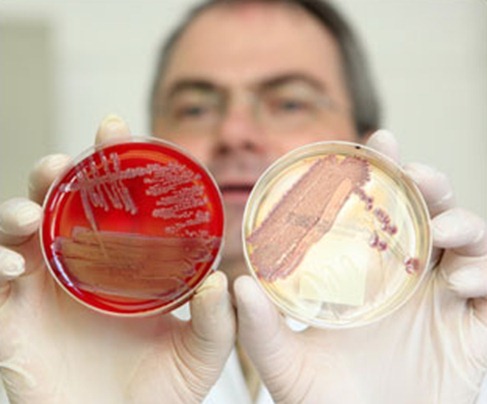
phpylpYXN

Una cepa de la bacteria E. Coli (Escherrichia coli) está causando muertes en Alemania y tiene alta resistencia a los antibióticos.
Esta cepa No procede de verduras como los pepinos españoles, las autoridades alemanas confirman el pepino importando de España No tiene nada que ver con el brote de E. coli. El pepino procedente de España es saludable y no tiene ningún riesgo para la salud. En De medicina os contamos más sobre la E. coli, y la cepa de la epidemia.

La fuente más probable de la epidemia según últimas noticias es una granja de soja en el norte de Alemania. En De medicina os contamos más sobre la E. Coli, una numerosa familia de bacterias, que han sido vitales en la investigación científica. La E. Coli vive en los organismos de sangre caliente, en su mayor parte es inofensiva.
La E. Coli está en nuestro intestino y en el de muchos animales, solo algunas variantes de E. Coli son peligrosas para los seres humanos. La E. coli está ya presente en nuestro organismo antes dela primera hora de vida. En muchos casos la E. coli sirve para desplazar a organismos más peligrosos.
La cepa E. coli de Alemania
- Sin embargo hoy es mundialmente famosa la E. Coli por los graves problemas que están sufriendo en Alemania, ya son más de 20 muertos y más de 600 afectados, en más de 11 países, muchos de ellos habían viajado recientemente a Alemania.

- Aunque la mayoría de las cepas de E. coli son inofensivas, algunas si con capaces de producir toxinas que pueden ser peligrosas en los seres humanos. Este es el caso de la cepa O104 de E. coli en Alemania.
- Esta cepa de E. Coli provoca el síndrome urémico hemolítico (SUH). El síndrome urémico hemolítico es una infección del aparato digestivo que produce sustancias tóxicas que destruyen los glóbulos rojos y causan lesiones a los riñones.
- Es una enfermedad grave que puede causar la muerte. Al parecer la cepa es muy resistente a los antibióticos, ni penicilina, ni sulfamidas ni cefalotina están logrando poder controlar esta cepa de E. coli.
- Con anterioridad algunos tipos de E. coli podían llevar a diarreas severas pero estos casos se vinculaban a la cepa 0157 y no parecían tener relación con la incidencia de casos en Alemania.
- En realidad las bacterias tiene capacidad de mutar, esta cepa de Alemania la O104 ya era conocida pero nunca en forma de brote. Al investigar se dieron cuenta que la bacteria había mutado era otra cepa dentro O104.

- Las bacterias son capaces de intercambiar genes entre diferentes cepas y especies , Ssta nueva cepa ha generado una bacteria con un comportamiento distinto. En este caso produce una toxina que puede dañar a los riñones y además se adhiere al intestino proliferando y aumentando la cantidad de toxina dentro del cuerpo.
- Expertos aseguran que la amenaza de esta cepa estriba en que estas bacterias pueden colonizar el agua de riego y la contaminación se puede dar también en el proceso de manipulación o envasado. Según Brendan Wren de la Escuela de Londres de HIgiene y Medicina Tropical, comenta que la E. coli se puede unir a los productos frescos.
- Estos tipos de bacteria E. coli pueden sobrevivir en condiciones más duras que las típicas E. coli. Además esta otra cepa puede producir toxinas peligrosas para el ser humano. Pueden sobrevivir en el suelo, y en los fertilizantes.

- El ganado puede llevar toxina E. coli en su intestino sin padecer la enfermedad, la toxina estará luego en sus heces. Si se usa por ejemplo estiércol contaminado con esta cepa de E. coli para abonar verduras, estás podrían contaminarse. Se han de lavar bien (agua y una gota lejío o producto apto para desinfectar), además pelar la verdura o fruta.
La E. Coli en la investigación
- Desde 1940 los científicos se dieron cuenta que la E. Coli podía aparearse, fueron capaces de hacer uno de los primeros mapas genéticos sobre la bacteria.
- En 1960 los investigadores descubrieron que se podía unir una sección del ADN dentro de la E. coli y añadir nuevos genes, de esta forma la bacteria replicaría esta nueva combinación de genes.

- La E. coli modificada ha sido clave para el desarrollo de muchos experimentos en el mundo. La E. coli se usa como micro fábrica, dando las instrucciones adecuadas puede ser modificada para producir proteínas o genes específicos. Es fácil de cultivar no requiere unas condiciones sofisticadas ni gran energía.
- En 1970 los científicos insertaron genes responsables de la codificación de la insulina humana a la E. coli, y de esta forma fueron capaces de producir en gran cantidad hormona para tratar la diabetes. Había nacido la biotecnología.
- La mayoría de las bacterias E. coli modificadas están diseñadas para no sobrevivir en nuestro organismo.
Si te gustó Comparte esta información en tus redes sociales o suscribete Gratis para recibir articulos sobre salud natural: